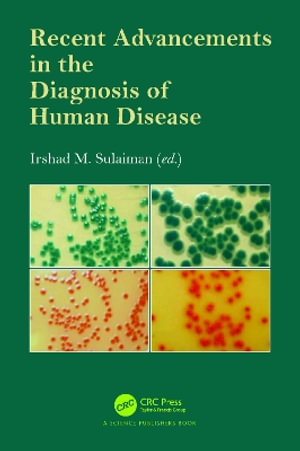
Recent Advancements in the Diagnosis of Human Disease - Irshad  M. Sulaiman

Recent Advancements in the Diagnosis of Human Disease
By: Irshad M. Sulaiman (Editor)
Paperback | 26 December 2025 | Edition Number 1
At a Glance
Paperback
$193.75
Available: 26th December 2025
Preorder. Will ship when available.
ISBN: 9781032572642
ISBN-10: 1032572647
Available: 26th December 2025
Format: Paperback
Language: English
Number of Pages: 304
Audience: College, Tertiary and University
Publisher: Taylor & Francis Ltd
Country of Publication: GB
Edition Number: 1
Dimensions (cm): 23.4 x 15.6 x 1.63
Weight (kg): 0.43
Shipping
| Standard Shipping | Express Shipping | |
|---|---|---|
| Metro postcodes: | $9.99 | $14.95 |
| Regional postcodes: | $9.99 | $14.95 |
| Rural postcodes: | $9.99 | $14.95 |
Orders over $79.00 qualify for free shipping.
How to return your order
At Booktopia, we offer hassle-free returns in accordance with our returns policy. If you wish to return an item, please get in touch with Booktopia Customer Care.
Additional postage charges may be applicable.
Defective items
If there is a problem with any of the items received for your order then the Booktopia Customer Care team is ready to assist you.
For more info please visit our Help Centre.
You Can Find This Book In
This product is categorised by
- Non-FictionSocial Services & WelfareCrime & CriminologyCriminal Investigation & DetectionForensic Science
- Non-FictionMedicineClinical & Internal MedicineDiseases & DisordersInfectious & Contagious Diseases
- Non-FictionScienceBiology, Life SciencesMolecular Biology
- Non-FictionEngineering & TechnologyBiochemical EngineeringBiotechnology
- Non-FictionMedicineOther Branches of MedicineEnvironmental MedicineTropical Medicine
- Non-FictionScienceBiology, Life SciencesZoology & Animal Sciences
- Non-FictionScienceBiology, Life SciencesHuman Biology
- Non-FictionScienceScience in GeneralScientific Equipment
- Non-FictionMedicineOther Branches of MedicinePathologyMedical Microbiology & Virology
























